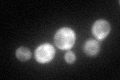
YIL138C
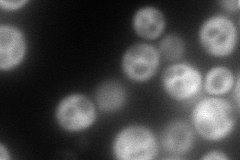
YIL138C
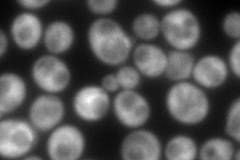
YIL138C
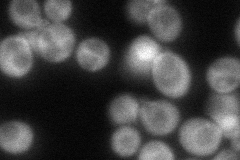
YIL138C
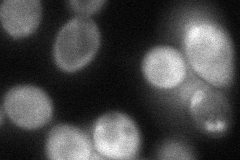
YIL138C
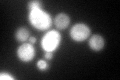
YIL138C
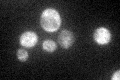
YIL138C

View description
Minor isoform of tropomyosin, binds to and stabilizes actin cables and filaments, which direct polarized cell growth and the distribution of several organelles; appears to have distinct and also overlapping functions with Tpm1p
Localization:
Intensity:
Fold change:
Significance:
-
C’ GFP library in SD
cytosol65.91 -
N' NOP1pr-GFP in SD
cytosol184.611 -
N' TEF2pr-mCherry in SD
cytosol265.284 -
N' NATIVEpr-GFP in SD
cytosol,punctate94.6505 -
N' TEF2pr-VC and Cyto-VN in SD
cytosol67.2016 -
C’ GFP library in SD+DTT
cytosol70.631.07No -
C’ GFP library in SD+H2O2

cytosol66.671.01No -
C’ GFP library in Starvation Media
cytosol57.580.87No -
C’ GFP library on the background of Pup2-DaMP

cytosol -
C’ GFP library on the background of CCT mutant

cytosol58.18780.882666No
